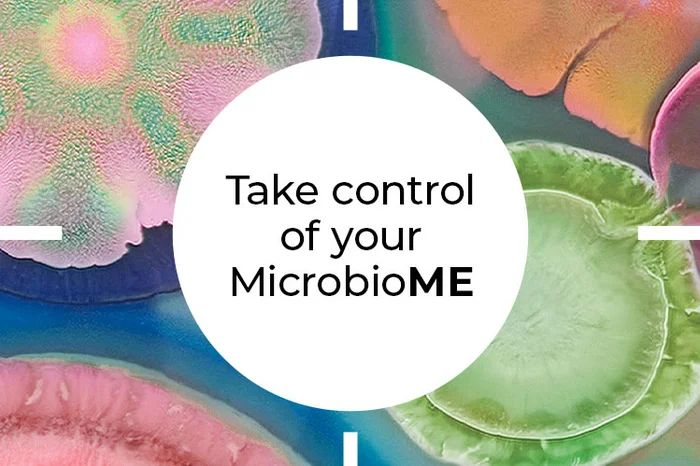
Take control of your MicrobioME

About PrecisionBiotics®
health problems. Our scientists began researching thousands of bacterial cultures together with experts from one of the world's leading centres of microbiome research,
the APC Microbiome Institute. From the very start, we have been dedicated to understanding unique bacterial strains and their role in specific areas of health.
Today, we are part of Novonesis OneHealth and working with human health centres of excellence across the world.
We have access to the world’s largest collection of bacterial strains and thousands of enzymes that help further our dedication to find sustainable solutions for future generations.
Our unique heritage and expertise allow us to look for one-in-a-trillion solutions and empower people to live healthier, happier lives.

Microorganisms that help you live your best life
That’s the essence of PrecisionBiotics. And it all starts with your microbiome.

As individual as you
And what’s truly amazing is that your microbiome is as unique as you are.

A data-driven scientific search

Be the best version of you
PrecisionBiotics® is one of the world’s most trusted food supplement brands, because we validate our products with robust, pioneering research studies which help us to understand the unique strains behind our products. We also provide a wealth of information and resources in our Health Hub to support you on your journey to a better gut microbiome.

Natural and effective results
Our products are validated with high quality research studies to ensure natural and effective results. We provide the exact bacterial strain in just the right amount, in combination with carefully chosen vitamin and minerals for individual health solutions. And we make it easy to choose the right supplement by tailoring our products to your specific needs.

The Importance of Gut Health
The gut microbiome has been described as the forgotten organ.
Scientists are just beginning to understand the complex relationships we have with the bacterial cultures in our gut microbiome, and the relationships they have with each other.
Many factors may disturb this delicate balance, including infections, use of antibiotics, everyday stress, digestive problems and inadequate nutrition. In the last decade, research has also shown the impact that gut bacteria can have on our ability to manage everyday stress and mood, also known as the gut-brain axis. Several of PrecisionBiotics® research partners are now involved in cutting-edge research in this area.
The One-in-a-trillion solution
In short, we find the one-in-a-trillion solution, combining unique, high quality products with expert information and resources, to empower people everywhere to take control of their personal health and microbiome. That’s how we put the me back in MicrobioME.